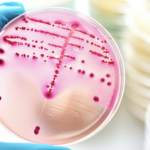
La sifilide: una malattia del passato?

Prostatectomia radicale: e poi?
Prostatectomia radicale: e poi?
Cosa è la prostata?
La prostata è una ghiandola che fa parte del sistema riproduttivo maschile. Si trova sotto la vescica e circonda una porzione dell’uretra, detta appunto uretra prostatica.
Quali sono le dimensioni della prostata?
La prostata ha dimensioni simili a quelle di una castagna.
Quale è la funzione principale della prostata?
E’ quella di secernere un fluido, chiamato secrezione prostatica, che nutre e protegge gli spermatozoi e che costituisce parte del liquido seminale.
Cosa si intende per “prostatectomia radicale”?
La prostatectomia radicale è una procedura chirurgica comunemente utilizzata per trattare il cancro della prostata clinicamente localizzato.
Cosa prevede questo intervento?
Questo intervento prevede la rimozione completa della ghiandola prostatica, delle vescicole seminali e talvolta dei linfonodi vicini, per eradicare completamente il tumore.
Love is Love:
Clinica della Coppia is LGBT Friendly
Quali tecniche vengono utilizzate?
Nel corso degli anni, i progressi nella tecnologia medica hanno portato allo sviluppo di varie tecniche per eseguire questa operazione, ed esistono vari tipi di prostatectomia:
- Prostatectomia radicale aperta : questo approccio tradizionale prevede un’incisione significativa nella parte inferiore dell’addome per accedere e rimuovere direttamente la ghiandola prostatica. Sebbene efficace, ora è meno comune a causa della sua invasività.
- Prostatectomia radicale laparoscopica : a differenza della chirurgia aperta, questo approccio minimamente invasivo utilizza piccole incisioni nell’addome per l’inserimento di strumenti e un endoscopio per guidare la procedura.
- Prostatectomia radicale robotica : questa tecnica, simile alla laparoscopia, utilizza l’assistenza robotica per una maggiore precisione e visualizzazione. Offre vantaggi come tempi di recupero ridotti e risultati migliori.
Intervista su Relazioni Familiari
Chi dovrebbe sottoporsi a questo intervento chirurgico?
In linea generale dovrebbe sottoporsi a trattamento chirurgico il paziente con malattia clinicamente localizzata e con aspettativa di vita di almeno 10 anni. Oggi, tuttavia, un rigido criterio di età non è più accettabile, alla luce del prolungamento della vita media.
Cosa aspettarsi dopo l’intervento chirurgico?
Dopo l’intervento chirurgico, i pazienti possono manifestare incontinenza urinaria temporanea e problemi di erezione, che spesso migliorano nel tempo.
Come si preserva la funzione erettile?
In questo caso vengono impiegate tecniche di risparmio dei nervi.
Festival della Coppia - La terapia di coppia dopo un tradimento
Seguici su:
Facebook Twitter
Ci sono dei rischi?
Come ogni intervento chirurgico importante, la prostatectomia radicale comporta rischi e potenziali complicanze.
Le complicanze possono essere: intraoperatorie, precoci (fino a 30 giorni dall’intervento) e a distanza (dopo 30 giorni dall’intervento).
Complicanze intraoperatorie
- emorragie con rischio di trasfusione del 4%
- lesioni rettali, rischio 0,1-0,2%
- lesioni al nervo otturatorio, rischio 0,1%
- lesioni uretrali rischio, 0,1-4%
Complicanze precoci
- trombo embolie 0,7-2,6%
- cardiovascolari 0,4-1,4%
- infezioni della ferita 0,9-1,3%
- linforrea e linfocele 0,6-2%
- stenosi dell’anastomosi uretrovescicale 0,6-32% dei casi.
(dati estratti dalle linee guida AURO).
Complicazioni a distanza
- Incontinenza fecale: rarissima e solo in caso di prostatectomia per via perineale.
- Incontinenza urinaria: dopo la rimozione del catetere vescicale è frequente un periodo di incontinenza urinaria. Tale fenomeno si risolve nel 95-96% dei pazienti (linee guida AURO). Il periodo necessario alla risoluzione del problema è variabile da alcuni giorni ad alcuni mesi e non è, ad oggi, prevedibile con nessuna delle tecniche chirurgiche descritte.
Quanto è diffuso il carcinoma prostatico?
Il carcinoma prostatico è il secondo tumore più comune tra gli uomini occidentali. La sua incidenza aumenta con l’età, raggiungendo l’apice intorno ai 70 anni.
Si può fare una diagnosi precoce?
Si. Negli ultimi decenni, le tecniche di screening avanzate hanno reso possibile una diagnosi precoce. Questo significa che gli interventi chirurgici vengono eseguiti in fasi più precoci della malattia, con esiti migliori, soprattutto per quanto riguarda l’attività sessuale.
Quanto è grave l’incontinenza urinaria dopo l’intervento?
Può variare di intensità, da lieve a grave, a seconda di vari fattori. Questo elemento può influenzare in modo significativo l’autostima del paziente e la sua capacità di mantenere un’intimità fisica e emotiva con la/il partner.
Cosa fare per risolvere l’incontinenza urinaria, nel caso fosse persistente?
Nei casi in cui l’incontinenza risulterà persistente si può ricorrere a:
- fisiochinesiterapia riabilitativa perineale;
- sostanze introdotte attraverso l’uretra, in grado di amplificare l’attività sfinterica e quindi correggere l’incontinenza;
- sling, ossia banderelle di materiale biocompatibile che poste a cavallo dell’uretra riducono il grado di incontinenza;
- sfintere artificiale, un meccanismo biomedico combinato che funge da nuovo sfintere e può essere comandato direttamente dal paziente.
Quanto è frequente la disfunzione erettile post prostatectomia?
Anche questa dipende da vari fattori: molto importanti sono la capacità erettile del paziente prima dell’intervento, la sua età anagrafica e la possibilità di eseguire una chirurgia radicale nerve-sparing (ossia con risparmio dei nervi durante la prostatectomia)

Dr. Giuliana Proietti Psicoterapeuta Sessuologa
Tel. 347 0375949
Dr. Walter La Gatta Psicoterapeuta Sessuologo
Tel. 348 3314908
Quando è consigliabile riprendere l’attività sessuale dopo l’operazione?
Durante il periodo postoperatorio, è consigliabile riprende-
re l’attività sessuale non appena possibile. L’erezione inizialmente non sarà spontanea, ma legata alla stimolazione sessuale. Nel corso dei primi mesi postoperatori il paziente potrà notare un progressivo miglioramento.
Ci si può aiutare con gli inibitori delle fosfodiesterasi?
Si. L’uso degli inibitori delle fosfodiesterasi può essere utile per sostenere l’erezione durante l’attività sessuale.
Cosa si può fare se non vi fosse una risposta soddisfacente?
E’ possibile ricorrere a microiniezioni di farmaci vasoattivi all’interno del corpo cavernoso con lo scopo di favorire l’ottenimento dell’erezione, oppure impiantare una protesi peniena permanente.
Ancona, Civitanova Marche, Fabriano, Terni, Online
Quanto è importante la figura del sessuologo per accompagnare questo percorso?
E’ fondamentale: accanto alla figura dell’andrologo occorre essere seguiti da un sessuologo, che può aiutare il paziente nel far fronte a nuovi problemi che influiscono sugli aspetti sessuali, come l’incontinenza e la disfunzione erettile.
Dr. Walter La Gatta
Fonte principale:
Humanitas, prostatectomia radicale
Immagine:
https://it.wiktionary.org/wiki/prostata

PSICOLOGO-PSICOTERAPEUTA SESSUOLOGO
Ancona Terni Fabriano Civitanova Marche e ONLINE
– Psicoterapie individuali e di coppia online
– Sessuologia (Sessuologia Clinica, individuale e di coppia)
– Tecniche di rilassamento e Ipnosi – Disturbi d’ansia, timidezza e fobie sociali
Per appuntamenti: 348 – 331 4908
Sito personale: www.walterlagatta.it
Altri Siti:
www.psicolinea.it
www.clinicadellatimidezza.it
www.festivaldellacoppia.it
www.walterlagatta.it
ISCRIVITI ALLA PAGINA FACEBOOK!
w.lagatta@psicolinea.it
Tel. 348 3314908